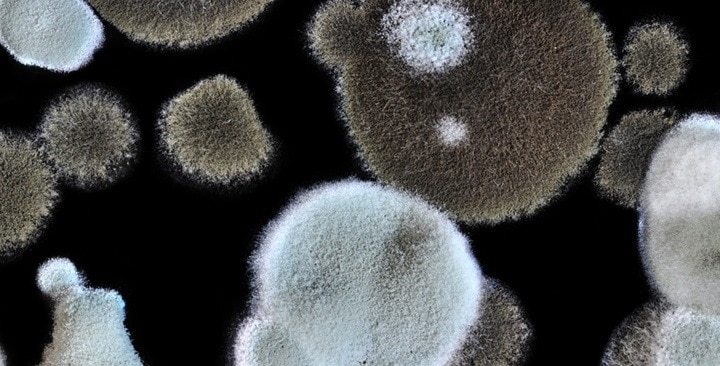
Mikroskopické plesne

PEĽ LIESKY
lat. Corylus, ang. Hazel
Rozkvitanie liesok sa považuje za začiatok botanického predjaria. Peľ liesok sa objavuje v januári a februári. Alergiu na peľ liesky zvyčajne sprevádza alergia na peľ brezy a jelše a intolerancia voči lieskovým orechom (prejavy potravinovej alergie).
PEĽ JELŠE
lat. Alnus, ang. Alder
Začiatok peľovej sezóny a jej intenzita závisí najmä od teploty vzduchu v zime a na začiatku jari. Peľ jelše sa v ovzduší objavuje v druhej polovici februára a v marci. Peľ jelše predstavuje po peli brezy druhú najčastejšiu príčinu sezónnej alergickej nádchy a alergického zápalu spojiviek v jarnom období. Citlivosť voči alergénom peľu jelše je často sprevádzaná citlivosťou na alergény peľu brezy a liesky.
PEĽ TOPOĽA
lat. Populuss, ang. Poplar
Topoľ je dvojdomý strom, čo znamená, že sa samčie a samičie kvety nevyskytujú na tej istej rastline. Kvety topoľov tvoria visiace jahňady, ktoré sa objavujú na začiatku jari, v marci a apríli, ešte skôr ako vyrastú listy. Na prelome mája a júna na samičích rastlinách dozrievajú plody obsahujúce semená s páperím. Dozrievanie plodov topoľa sa časovo zbieha so začiatkom výskytu peľov tráv. Veľa alergikov citlivých na pele tráv si myslí, že príčinou ich ťažkostí je biele páperie topoľov, ktoré však nie je alergén.
PEĽ BREZY
lat. Betula verrucosa, ang. Common silver birch
Alergény peľu brezy sú po alergénoch peľu tráv najčastejšou príčinou polinózy a atopickej peľovej astmy. Peľ brezy sa vyskytuje v apríli a v máji. Peľ brezy dosahuje v ovzduší veľmi vysoké koncentrácie – až niekoľko tisíc zrniek na 1 meter kubický vzduchu.
Alergiu na peľ brezy zvyčajne sprevádza citlivosť voči peľu liesky a jelše.
PEĽ HRABU
lat. Pinus, ang. Pine
Samčie kvety hrabu tvoria jahňady, ktoré rozkvitajú od polovice apríla do začiatku mája spoločne s rastom listov. Citlivosť voči alergénom peľu hrabu je zriedkavá, ale jeho alergény môžu vykazovať skrížené reakcie s alergénmi peľu brezy a násobiť tak príznaky u osôb alergických aj na kvety brezy.
Koncentrácia peľu hrabu v mestách zvyčajne neprekračuje priemerné hodnoty.
PEĽ DUBU
lat. Quercus, ang. Oak
Na Slovensku sa najčastejšie vyskytujú 2 druhy. Dub letný a dub zimný, ktoré kvitnú v apríli a v máji.
Ďalšie druhy: dub cerový, dub červený – môžeme ich často vidieť v parkoch, v rámci pouličnej zelene a pri cestách. Klinický význam alergénov dubového peľu je priemerný.
PEĽ BOROVICE
lat. Pinus, ang. Pine
Alergénna aktivita peľu borovice a smreku je podľa väčšiny autorov nevýrazná alebo žiadna. Vzhľadom na mimoriadne vysoké koncentrácie peľu borovice môže poškodenie sliznice neskôr negatívne ovplyvniť príznaky vyvolávané alergénmi peľu tráv. Po dažďoch sa v období výskytu peľu borovice (máj) na okrajoch mlák objavuje žltá usadenina, ktorú tvorí najmä peľ borovice.
PELE TRÁV
lat. Poaceae, Gramineae, ang. Grasses
Alergény peľu tráv sú najčastejšou príčinou alergickej nádchy a atopickej peľovej astmy. Hlavné obdobie výskytu peľu tráv pripadá v strednej Európe na druhú polovicu mája, jún a prvú polovicu júla, v severnej Európe je to druhá polovica júna, júl a prvá polovica augusta, v južnej Európe a Stredozemí máj. Okrem rozdielu v termínoch výskytu peľov tráv sú ešte v rôznych klimatických zónach zaznamenávané aj významné rozdiely v dĺžke peľovej sezóny a rozdiely v dosahovaných priemerných a maximálnych koncentráciách peľu.
Peľová sezóna tráv pripadá na obdobie mája až septembra, ale prvé peľové zrná tráv sa vo vzduchu objavujú už v apríli.
PEĽ SKOROCELU
lat. Plantago, ang. Plantain
Skorocel je opeľovaný hmyzom alebo vetrom. Koncentrácie jeho peľu nikdy nedosahujú príliš vysoké hodnoty. Skorocel kopijovitý a skorocel prostredný kvitnú v máji a júni, skorocel väčší v júli.
PEĽ ŽIHĽAVY
lat. Urtica, ang. Nettle
Žihľava produkuje značné množstvo peľu a má dlhú peľovú sezónu (jún až október), pričom koncentrácie jej peľu v atmosfére dosahujú veľmi vysoké hodnoty. Citlivosť voči alergénom peľu žihľavy sa vyskytuje zriedka.
PEĽ PALINY
lat. Corylus, ang. Hazel
Citlivosť voči alergénom peľu paliny je častou príčinou alergickej nádchy a zápalu spojiviek (po peľoch tráv a brezy). Väčšina prejavov tzv. sennej nádchy v neskorom lete je vyvolaná práve alergénmi peľu paliny.
Peľová sezóna je v období júla až októbra. Hlavné alergény peľu paliny vyvolávajú skrížené reakcie s množstvom ďalších rastlinných alergénov. U časti pacientov citlivých na alergény peľu paliny bývajú pozorované prejavy orálneho alergického syndrómu (OAS) po požití niektorých druhov ovocia a zeleniny. Najčastejšie býva uvádzaná intolerancia voči zeleru, jablkám, mrkve, bylinkám (najmä harmančeku) a koreniu.
PEĽ AMBRÓZIE
lat. Ambrosia, ang. Common ragweed
Alergén peľu ambrózie je najčastejšou príčinou alergickej nádchy v Severnej Amerike, odkiaľ bola zavlečená do Európy. Dlhé roky sa tradovalo, že v Európe nepredstavuje žiadny problém. Ambrózia kvitne od júna do októbra. Na Slovensku bola zistená prítomnosť troch druhov ambrózie: ambrózia palinolistá (Ambrosia artemisiifolia L.), ambrózia lysoklasá (Ambrosia psilostachya DC.), ambrózia trojzárezová (Ambrosia trifida).
MIKROSKOPICKÉ PLESNE
Huby predstavujú obrovskú, pomerne rozšírenú skupinu organizmov, ktorá tvorí jednu z piatich ríš zahŕňajúcich všetky živé organizmy. Časti húb, spóry a fragmenty podhubia pochádzajúce z rôznych zdrojov, môžu byť zdrojom množstva alergénov. Z epidemiologických výskumov vyplýva, že huby rodu Alternaria, Cladosporium, Penicillium a Aspergillus predstavujú najzávažnejší zdroj plesňových alergénov. Najčastejšou príčinou hypersenzitívnych reakcií sú alergény rodu Alternaria alternata, aj keď u väčšiny pacientov existuje precitlivenosť na alergény niekoľkých druhov plesní.
Spóry plesní rodu Alternaria
Pleseň rodu Alternaria alternata je celosvetovo rozšírená. Vďaka svojim životným potrebám je schopná kolonizovať povrchové vrstvy pôdy, odumierajúce rastliny a predstavuje patogén pre viacero druhov rastlín. Pre rast plesne je priaznivá vysoká vlhkosť vzduchu a mierne zvýšená teplota. Pri množení pleseň vytvára spóry, ktoré uvoľňuje do okolia. Spóry plesne Alternaria patria k tzv. suchým, ktoré sa uvoľňujú do okolia pasívne, nezávisle od meteorologických podmienok ako napríklad rýchlosť vetra. V zimných mesiacoch, keď zemský povrch pokrýva snehová vrstva a teplota klesá, sa spóry Alternaria alternata vo vzduchu nevyskytujú. Alergény spór Alternaria sú medzi alergénmi plesní najčastejšou príčinou alergickej nádchy a alergickej astmy. Ich sezóna vrcholí v júli a auguste, kedy môžu koncentrácie spór dosahovať až niekoľko stoviek v 1 metri kubickom vzduchu.
Spóry plesní rodu Cladosporium
Rod Cladosporium je jedným z najčastejších typov, ktoré sa vyskytujú vo vzduchu takmer na celom svete. Spóry rodu Cladosporium majú drobné rozmery a dosahujú veľmi vysoké koncentrácie v ovzduší.